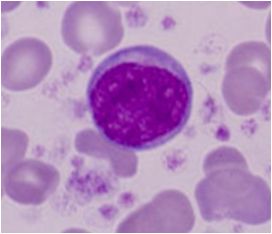

![]() |
| www.pinterest.com |
Relación N/C: abundante citoplasma 5:1.
Coloración: núcleo rojo a purpura (ni basófilo ni acidófilo), el citoplasma se tiñe de azul claro y azul semi- obscuro.
Otros: posee un núcleo redondo u oval, puede poseer ligaras hendiduras, gneralmente s observa un nucleolo (redondo azul). a veces se pueden observar gránulos azurófilos.
(Miale, 2001)
Miale, J., (2001), Hematología, medicina de laboratorio, (6a. edición), España: Editorial Reverte. S:A.
Mi herpes y diabetes se curaron por completo después de tomar las medicinas herbales que el Dr. Jekawo preparó y me envió por correo electrónico. Nunca supe que existía un herbolario tradicional con tanta sabiduría ancestral capaz de curar todo tipo de enfermedades e infecciones con hierbas medicinales hasta que encontré al Dr. Jekawo en línea.
ResponderEliminarMe sentí muy frustrado cuando descubrí al Dr. Jekawo en línea leyendo blogs. Luego leí muchos testimonios sobre cómo usa hierbas medicinales para curar el herpes, la diabetes, el cáncer, el VPH, la hepatitis, la leucemia, el linfoma, la anemia, el agrandamiento del pene, el agrandamiento de los senos, la disfunción eréctil, hechizos de amor para recuperar a tu pareja, hechizos de buena suerte, la clamidia y el lupus. El Dr. Jekawo reside en África Occidental, pero también envía sus medicinas herbales a pacientes de todo el mundo. Él me envió las mías y me enseñó a tomarlas durante 20 días. Después de tomarlas, me hice una prueba y descubrí que me había curado definitivamente y que ya no tengo brotes. He recomendado al Dr. Jekawo a mis amigos y se han curado, así que creo que debería escribir esto aquí para que cualquier persona con problemas de salud se ponga en contacto con el Dr. Jekawo a través de www.drjekawo.com y por correo electrónico: drjekawo@gmail.com. Sin duda, curará a cualquier persona con infecciones o enfermedades y también atenderá problemas espirituales. ¡Mucha suerte!